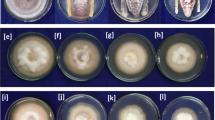

Abstract
In the present study, 129 rhizospheric bacteria isolated from Curcuma longa were screened for their antagonistic potential against six fungal phytopathogens. Among them, 32 isolates that showed significant antagonistic potential were screened for their in vitro plant growth promoting (PGP) traits. The identification of potential isolates was confirmed by 16S rRNA gene sequencing and results revealed Bacillus as the dominant genus followed by Staphylococcus, Pseudomonas, Sphingomonas and Achromobacter. Based on the antagonistic activity and PGP traits; two strains (BPSRB4 and BPSRB14), identified as Bacillus amyloliquefaciens, were further tested for their in vivo PGP and disease suppression potential on Capsicum annuum seedlings under greenhouse conditions. The results demonstrated that BPSRB4 and BPSR14 strains suppress fungal pathogen infection and promote plant growth. Further, the BPSRB4 strain was positive for the production of the phytohormone indole acetic acid (IAA) detected by thin layer chromatography (TLC). In addition, nitrogen fixation and plant growth promotion activity were also confirmed by amplification and sequencing of nitrogen fixation gene (nifH) and ACC (1-aminocyclopropane-1-carboxylate) deaminase (acdS) gene from strains BPSRB4 and BPSRB14. The present study demonstrated that the B. amyloliquefaciens strains BPSRB4 and BPSR14 possess antagonistic activity and PGP potential which could be explored for the development of biofertilizers and biocontrol agents for the growth of chilli seedlings.
Similar content being viewed by others
Avoid common mistakes on your manuscript.
Introduction
Turmeric (Curcuma longa) is a widely cultivated rhizomatous perennial crop, belonging to the family Zingiberaceae which can be used as a part of Siddha medicine (Chattopadhyay et al. 2013). It is well known for its medicinal properties, including antibacterial and antiseptic activity for cuts, or for indigestion, osteoarthritis, burns and bruises (Gregory et al. 2008). The rhizosphere, a narrow region surrounding and influenced by plant roots, contains a huge number of microorganisms capable of having beneficial, neutral or detrimental effects on plant growth (Philippot et al. 2013). Plant growth promoting rhizobacteria (PGPR) can be beneficial for plants by stimulating growth hormones and by suppressing disease prevalence (Shanmugam and Kanoujia 2011). PGPR have been known to enhance availability of nutrients (Drogue et al. 2012) and phytohormone mediated stimulation of root systems (Somers et al. 2004), and induce systematic resistance (Zehnder et al. 2000). Moreover, it has now been demonstrated that microbes obtained from one plant can be applied to other plants for promoting plant growth activity and disease resistance (Abbamondi et al. 2016; Passari et al. 2015b). Therefore, it is important to evaluate the potential of indigenous bacterial populations associated with turmeric rhizosphere soil for growth promotion in this and other crops.
PGPR promote plant growth under both biotic and abiotic stresses; therefore the use of PGPR can assist in increasing eco-friendly practices for sustainable agriculture. For instance, gram-positive and gram-negative bacterial genera such as coryneform bacteria, B. subtilis, Klebsiella, Burkholderia, Pseudomonas gladioli and Pseudomonas cepacia, Azospirillum, Azotobacter, Arthrobacter, Micrococcous, Enterobacter, and Xanthomonas have been reported to induce plant growth (El-Sayed et al. 2014; Bal et al. 2013). PGPR have been well documented previously from different agricultural crops like rice (Sudha et al. 1999), tomato (Mena-Violante and Olalde-Portugal 2007), sugarcane (Hassan et al. 2010), maize (Biari et al. 2008) and chilli (Datta et al. 2010). However, PGPR from the turmeric rhizosphere is still poorly explored. Knowledge of indigenous bacterial populations, their characterization and identification is required to understand their assemblages in the rhizosphere of specific crops (Breidenbach et al. 2016). The use of agrochemicals has reduced soil fertility in the northeast region of India by the accumulation of toxic chemicals in the soil. Hence, we endeavored to search for region-specific microbial strains from turmeric rhizosphere with plant growth promoting (PGP) activity and disease suppression potential (Deepa et al. 2010). The main objectives for this work were: (1) to isolate and identify potential plant growth promoting bacterial species from rhizospheric soil of C. longa; (2) to screen their in vitro antagonistic and PGP abilities; (3) to test their activity for production of lytic enzymes and detect genes for activities related to plant growth promotion; and (4) to evaluate the in vivo plant growth promotion and disease suppression potential on chilli seedlings.
Materials and methods
The study areas and sample collection
Rhizospheric soil and root samples of Turmeric plants (C. longa) were randomly collected from Dampa Tiger Reserve Forest [Dampa TRF] (23°25′N; 92°20′E) and Reiek Mountain hill forest (23°69′N; 92°62′E) district in Mizoram, India. The soil samples were red and yellow in colour with loamy texture. Each plant rhizosphere was carefully removed with the intact root system. The samples were placed in sterile Himedia plastic bags and carried to the laboratory on ice and processed immediately.
Isolation and primary identification of rhizospheric bacteria
Isolation of bacterial populations was carried out using serial dilution technique (Manivannan et al. 2012). Pure cultures were stored in 20% glycerol at -80 °C. Primary identification of bacteria was carried out based on morphological, biochemical and physiological characteristics according to Bergey’s Manual of Determinative Bacteriology (Bergey and Holt 2000).
Antagonistic activity of rhizospheric bacterial isolates
All the isolates were screened for their antagonistic activity against six plant pathogens i.e. Fusarium proliferatum (MTCC-286), Fusarium oxysporum f sp. pisi (MTCC-2480), Fusarium oxysporum f. sp. capsici (ATCC-66421), F. udum (MTCC-2755), Rhizoctonia solani (MTCC-9666) and Colletotrichum capsici (MTCC-8473) by using dual culture method (Bredholdt et al. 2007). Briefly, 5 mm potato dextrose agar (PDA) block with fungal growth was placed at the center of a petri plate containing PDA and the bacterial isolates were streaked at the periphery of the plates. Dual cultures were incubated at 28 °C for 7 days and the diameter of fungal mycellial growth was measured and compared to the control (without any bacterial isolate). The percentage of inhibition was calculated as: % inhibition = [1-(Fungal growth /Control growth)] ×100. The pathogens were obtained from the Microbial Type Culture Collection, Institute of Microbial Technology (IMTECH), Chandigarh, India. All experiments were carried out in triplicates and repeated twice.
Plant growth promoting abilities of rhizospheric bacterial isolates
Phosphate solubilization
All isolates were screened for their ability to solubilize insoluble phosphate by spot inoculation onto Pikovskayas agar (PKV) plates supplemented with rock phosphate (P2O5), an insoluble phosphate source (Nautiyal 1999).
Characterization of indole acetic acid (IAA) production
Bacterial isolates were screened for IAA production using nutrient broth supplemented with 0.2% L-tryptophan according to Bric et al. (1991). The concentration of IAA was calculated using a standard curve with indole-3-acetic acid. The experiments were repeated twice with three replicates each and means were calculated.
Detection of IAA by using thin layer chromatography (TLC)
Isolate BPSRB14 was grown in LB broth supplemented with 0.01% tryptophan and incubated at 37 °C, 150 rpm for 2 days. The culture was extracted thrice with ethyl acetate. The ethyl acetate extract was evaporated to dryness under pressure at 45 °C using a rotary evaporator (BUCHI, India) to obtain the crude extract. Ten (10) μl of bacterial (BPSRB14) crude ethyl acetate extract and standard IAA (10 mg/100 ml) was spotted onto TLC plates, and separated in a solvent containing, propanol: water (8:2) for 2 h. After the plates were dry, the indole compounds were developed by spraying chromogenic reagent (Salkowski reagent) in an upright position followed by heating to 90 °C. The Rf value was calculated based on mobility as compared to the standard (Mohite 2013).
Screening for ammonia, siderophore and catalase production
The rhizospheric bacterial isolates were tested for the production of ammonia as previously described (Cappucino and Sherman 1992). Siderophore production was evaluated using CAS agar medium supplemented with chrome azurol S (Schwyn and Neilands 1987). Catalase production by all isolates was performed as per Kumar et al. (2012a).
Estimation of Carboxymethyl Cellulase (CMCase), amylase and xylanase activities
Cellulase activity was screened on CMC agar medium containing (K2HPO4−0.5 g, MgSO4·7H2O - 0.25 g, carboxymethyl cellulose - 15.0 g and agar - 20.0 g) per litre of distilled water. The bacterial isolates were streaked onto CMC agar plates and incubated at 30 °C for 3–5 days, then 5 ml of congo red solution (1 mg/ml) was added to the plates. The plates were distained with 1 M NaCl for 15 min. A clear zone of hydrolysis indicated cellulase production (Teather and Wood 1982). Amylase activity was screened on Luria-Bertani (LB) agar medium containing 1% soluble starch. After growing bacteria at 30 °C for 5 days, 5 ml (1%) iodine solution was added to the plates, and a clear zone around the colonies indicated amylase production (Hankin and Anagnostakis 1975). For the xylanase activity, oat spelt agar medium containing 1% oat spelt was used. Each bacterial isolate was streaked onto the medium and incubated at 37 °C for 3–5 days. Thereafter, the plates were flooded with congo-red solution (1 mg/ml) for 10 min. Followed by destaining with 1 M NaCl for 15 min, and the appearance of a clear zone indicated xylanase production.
For quantitative estimation of cellulase, amylase and xylanase, each bacterial isolate was inoculated in tryptone yeast extract (ISP1) broth and incubated at 37 °C for 2–3 days using the 3,5-dinitrosalicylic acid (DNS) method according to Ghose (1987). The culture was centrifuged at 5000 rpm for 10 min and the cell free supernatant was collected for the enzymatic assay. The crude enzyme extract (0.5 ml) was mixed with 0.5 ml of specific substrates (1% of carboxymethyl cellulose for cellulase, soluble starch for amylase or xylan in 50 mM of phosphate buffer, pH -6.9 for xylanase). The mixture was incubated at 50 °C for 30 min and the reaction was stopped by the addition of 3 ml DNS reagent. Following, the mixture was boiled for 5 to 10 min and then 1 ml of sodium potassium tartarate (called Roselle salt) was added. The absorbance was recorded at 540 nm using a spectrophotometer (Thermo scientific Multiskan GO microplate reader). The enzyme activities were estimated using a standard graph of glucose. The one unit of enzyme activity was defined as the amount of enzyme that released 1 μM of glucose per min (Ariffin et al. 2006).
Molecular characterization and phylogenetic analysis of rhizospheric bacteria
PCR amplification of 16S rRNA gene and sequencing
PCR amplification of the 16S rRNA region of bacterial isolates was carried out by using universal primers- PA: 5′-AGA GTT TGA TCC TGG CTC AG-3′) and PH: 5′-AAG GAG GTG ATC CAG CCG CA-3′ (Qin et al. 2009). The amplified PCR products were analyzed by electrophoresis through 1.5% agarose gels and documented using a Bio-rad Gel Doc XR+ system (Hercules, CA, USA). The PCR products were purified using Pure-link PCR Purification Kit (Invitrogen), and was sequenced commercially at Sci-Genome Labs Pvt. Ltd., India.
Phylogenetic analysis of rhizospheric bacteria
The 16S rRNA gene sequences were compared with the National Center for Biotechnology Information (NCBI) database using the BlastN search program. The species showing 98–100% sequence identity were selected as close matches. The sequences were aligned using Clustal W (Thompson et al. 1997). All the sequences were submitted to NCBI Genbank and accession numbers were obtained. A maximum-likelihood phylogenetic tree was constructed by Kimura 2- parameter model using MEGA 5.05. Sequences from E. coli (gram-negative bacteria) and Kocuria rhizophila (gram-positive bacteria) were included as outgroups for the analysis (Saitou and Nei 1987). The reliability of the phylogenetic trees was evaluated by bootstrap analysis with 1000 resamplings using p-distance model (Felsenstein 1985).
Detection of nitrogen fixation (nifH) and ACC deaminase (acdS) encoding genes in rhizospheric bacteria
The nifH gene was amplified using nifH1 forward primer (5′-CGTTTTACGGCAAGGGCGGTATCGGCA-3′) and nifH2 reverse primer (5′-TCCTCCAGCTCCTCCATGGTGATCGG-3′) as described by Pandey et al. (2004).
The Acc deaminase gene (acdS) was amplified using the forward primer 5′- GGCAAGGTCGACATCTATGC-3′ and reverse primer 5′-GGCTTGCCATTCAGCTATG-3′ as per Antoun and Prevost (2005). The PCR products were purified using a Quick PCR purification kit (GeneiPure, Merk) and sequencing was done commercially at Sci-Genome Pvt. Ltd. Kochin, India.
Ad planta
Preparation of planting material and bacterial inoculum
Chilli (Capsicum annuum) seeds (PUSA-Jwala, collected from the Indian Agricultural Research Institute (IARI), New Delhi, India) were surface sterilized in 70% ethanol for 5 min followed by 2% NaOCl for 3 min and then, washed three times with sterile distilled water. The rhizospheric isolates BPSRB 4 and 14, were evaluated for in vivo plant growth promoting activity on chilli seed. Bacterial isolates grown overnight in LB broth at 37 °C at 150 rpm were used as bacterial inoculum for PGP effect.
Plant growth promoting (PGP) assay
Chilli (C. annuum) seeds of the cultivar PUSA-Jwala were soaked overnight in sterile distilled water and were planted in a plug tray using nursery substrates until three to four leaves emerged. Individual seedlings were transferred to plastic pots filled with soil. The seedlings were grown under greenhouse conditions, temperatures ranging from 25 to 30 °C and the humidity between 75 and 90%. The experiment was carried out in a randomized design. Three treatments were used in PGP assay: TA1- seedlings without any inoculum (control), TA2- seedlings + isolate BPSRB4 inoculum and TA3- seedlings + isolate BPSRB14 inoculum. Each treatment included three replications with ten plants per replica. Root length, shoot length and fresh plant weight measurement were recorded after 30–45 days between inoculated and uninoculated plants (Ji et al. 2014). Each treatment included three replications with ten plants per replica. Five plants from each treatment were removed to measure the growth measuring parameters at 30 and 45 days. All treatments were carried out twice a week and plants were watered once daily until harvesting. Data were statistically analyzed using standard analysis of variance (ANOVA) and Duncan’s multiple comparison tests at P ≤ 0.05.
Biocontrol activity
Chilli (C. annuum) seeds of the cultivar PUSA-Jwala were soaked overnight in sterile distilled water and similarly treated as described above. The experiment was carried out in a completely randomized design. Two potential strains (BPSAC4 and BPSAC14), based on their in vitro screening, were selected for in planta activity against F. oxysporum f. sp. capsici, the major causative agent of Fusarium wilt in chilli. Three treatments were performed to promote disease development under greenhouse conditions: TB1- seedlings + conidial suspension of F. oxysporum f. sp. capsici (control); TB2- seedlings + isolate BPSRB4 inoculum + conidial suspension of F. oxysporum f. sp. capsici, TB3- seedlings + isolate BPSRB14 inoculum + conidial suspension of F. oxysporum f. sp. capsici.. Five plants from each treatment were removed to confirm their disease suppression potential of the bacterial strains compared with control after 30 and 45 days. All treatments were carried out twice a week and plants were watered once daily till harvesting.
The percent disease index was calculated according to Shanmugam and Kanoujia (2011) as follows:
Where, R = rating × number of plants rated.
The wilt development of each chilli plant was rated as described; 0 = no symptoms; 1 = <25% of leaves with symptoms; 2 = 26–50% of leaves with symptoms; 3 = 51–75% of leaves with symptoms; 4 = 76–100% of leaves with symptoms. Disease index data were statistically analyzed.
Statistical analysis
The data obtained was analyzed using standard analysis of variance (ANOVA) generalized linear model (GLM) followed by Duncan’s multiple comparison test at p < 0.05. All treatments were carried out in triplicate and the results are presented as mean ± standard deviation (SD). Mean values were separated by using the least significant difference (LSD) test.
Result
Isolation and morphological identification of rhizospheric bacteria
A total of 129 isolates were obtained from the rhizospheric soil samples collected from Dampa Tiger Reserve forest and Reiek mountain hill forest Mizoram. Based on Gram staining, 96 isolates were found to be Gram positive and 33 isolates were Gram negative. Biochemical analysis revealed that all the isolates were positive for the catalase and starch hydrolysis tests. Relative abundance of rhizospheric bacteria indicated that Bacillus sp. was the most dominant genus at Dampa TRF (63.1%) followed by Reiek with 36.8%. The genus Staphylococcus was most abundant in Reiek (80.0%) followed by Dampa TRF (20.0%) (Fig. 1). The genus Achromobacter was prevalent only in Dampa tiger reserve forest of Mizoram.
In vitro antagonistic activity of rhizospheric bacteria
Among, 129 rhizospheric bacterial isolates, 32 showed positive antagonistic activity against more than two fungal phytopathogens out of the six fungal phytopathogens tested with the percentage of inhibition ranging from 31% to 89%. All isolates showed antagonistic activity against F. oxysporum f. sp. capsici, the major pathogen responsible for the Fusarium wilt in chilli, whereas F. udum was the most susceptible fungal pathogen against most of the rhizospheric bacteria isolates with an exception of 6 isolates (BPSRB 2, 3, 4, 7, 10 and 14). Isolate BPSRB4 showed strong activity against F. proliferatum (85%), whereas isolate BPSAC 14 exhibited the greatest antagonism potential against F. oxysporum f. sp. capsici (89%) and F. oxysporum f. sp. pisi (84%) (Table 1).
Plant growth promoting traits of antagonistic rhizospheric bacteria
Phosphate solubilization and IAA production
Among 32 antagonistic positive isolates, 26 showed phosphate solubilization activity based on their solubilizing capacity of rock phosphate (P2O5) by producing a clear halo zone around the spotted bacterial colonies on Pikovskaya’s medium. The zone of phosphate solubilization of rhizospheric bacteria varied from 1.0 to 12.4 mm. Isolate BPSRB4 showed the highest phosphate solubilization activity with P solubilization zone of 12.4 mm, followed by BPSRB14 (10.5 mm) and BPSRB2 (9.5 mm) (Table 2).
The IAA screening results showed that 28 isolates (87.5%) were positive for IAA production. The quantitative estimation of the IAA production in culture broth in the presence of tryptophan ranged from 16.8 to 60.5 μg/ml. The IAA yields of isolates BPSRB4 and BPSRB14 were 60.5 μg/ml and 59.4 μg/ml, respectively, which was the highest among all the isolates tested (Table 2). Moreover, the Rf value of isolate BPSRB4 on TLC plate was equivalent to standard IAA (0.57).
Ammonia, Siderophore and catalase production
Quantitative estimation of ammonia production by all the isolates showed positive results in peptone water broth, and ranging from 15.4 to 72.3 mg/100 ml. Isolate BPSRB4 produced the greatest amount of ammonia (72.3 mg/100 ml) followed by BPSRB14 (69.8 mg/100 ml) and BPSRB2 (67.4 mg/100 ml). Out of 32 isolates, 23 (71.8%) had a clear orange halo zone around the colonies on CAS agar media. Isolate BPSRB4 showed the highest siderophore production followed by BPSRB14 and BPSRB2. All the isolates were positive for catalase production as indicated by effervescence after the addition of H2O2 on bacterial culture which was grown for 48 h on LB agar medium (Table 2).
Cellulase, amylase and xylanase production assays
The 32 antagonistic positive isolates were further screened for the qualitative production of cellulase, amylase and xylanase, out of which 27 (84.3%) isolates were positive for cellulase and xylanase production, whereas, 29 (90.6%) isolates showed amylase production. The cellulase, amylase and xylanase production ranged from 1.84 to 7.86 IU/ml, 1.62 to 8.24 IU/ml and 1.56 to 7.42 IU/ml, respectively. Among the positive isolates, isolate BPSRB4 showed the highest cellulase (7.86 IU/ml) and amylase (8.24 IU/ml) production; however the highest xylanase (7.46 IU/ml) production was detected in isolate BPSRB14 (Table 2).
Identification and molecular characterization of bacterial isolates
In order to confirm the identity of all 32 antagonistic positive isolates, 16S rRNA gene sequencing was carried out. The results of DNA sequencing classified all the isolates into five genera; Bacillus (56.25%), Staphylococcus (15.6%), Pseudomonas (12.5%), Sphingomonas (9.3%) and Achromobacter (3.1%) (Table 3). The nucleotide sequences were further compared by BLASTn analysis tool to look for 16S rRNA gene homology along with sequences from type strains retrieved from EzTaxon-database (http://www.ezbiocloud.net/eztaxon). The nucleotide sequences were deposited in NCBI Genbank database under the accession numbers KT028674 to KT028688 and KU158218 to KU158234 (Table 3).
The phylogenetic tree of gram positive bacterial nucleotide sequences using Maximum-likelihood method with kimura 2-parameter model (the estimated transition/transversion bias, R = 1.52) is shown in Fig. 2. The model was selected based on lowest BIC values. The phylogenetic tree divided turmeric rhizospheric bacterial isolates into two different clades (Clades I and Clades II) with bootstrap value 74%. The rhizospheric bacterial isolates in Clade I, were further divided into two small clades (Clade IA and Clade IB) under a bootstrap support value of 59%. Most of the isolates formed a major clade IA belonged to the Bacillus group, along with type strains from EzTaxon databases with bootstrap value of 69%. All the Staphylococcus sp. in Clade IB were closely related with a bootstrap value of 74%. In clade II were all the Lysinibacillus sp. with type strains with a bootstrap value of 74%.
Phylogenetic relationships based on partial 16S rRNA gene sequences from PGPR rhizospheric Gram positive bacterial isolates with reference strains from EZ-Taxon database. The phylogenetic tree was constructed using maximum-likelihood method. A bootstrap analysis was performed with1000 replicates. The red stars indicate gram-positive rhizospheric bacteria isolated from C. longa
The phylogenetic tree with gram negative bacterial nucleotide sequences using Maximum-likelihood method with kimura 2-parameter model (the estimated transition/transversion bias, R = 1.52) is shown in Fig. 3. All the isolates were separated into two clades (clade I and clade II) with bootstrap support value of 88%. In clade I, all the isolates were closely related and they belonged to Pseudomonas sp. and Achromobacter sp., whereas clade II consisted of three isolates belong to Sphingomonas sp.
Phylogenetic relationships based on partial 16S rRNA gene sequences from PGPR rhizospheric Gram negative bacterial isolates with reference strains from EZ-Taxon database. The phylogenetic tree was constructed using neighbor-joining method. A bootstrap analysis was performed with 1000 replicates and the scale bar indicates 0.05 substitutions per site. The blue diamonds indicate gram-negative rhizospheric bacteria isolated from C. longa
Detection of nitrogen fixation (nifH) and ACC deaminase (acdS) encoding genes in rhizospheric bacteria
Out of 32 isolates, 12 isolates showed amplification of the nifH encoding gene and the desired amplified fragment of about 780 bp was obtained (Fig. 4a). The fragments obtained from strains BPSRB4 and 14 were sequenced and submitted to NCBI GenBank with accession numbers KX709838 and KX709839. The sequenced fragments from strains BPSRB4 and BPSRB14 showed 98% homology with other nifH gene using BLAST analysis.
A Polymerase chain reaction (PCR) based detection of nitrogen fixation (nifH) encoding gene; M: low range DNA ruler (3 kb-100 bp); 1 to 32 represents rhizospheric bacterial isolates. 4B Polymerase chain reaction (PCR) based detection of ACC deaminase (acdS) encoding gene. M: low range DNA ruler (3 kb-100 bp); 1 to 26 represents rhizospheric bacterial isolates
Out of 32 isolates, 12 isolates showed amplification of a fragment size of 1000 bp which is consistent with the acdS gene responsible for ACC deaminase activity (Fig. 4b). The fragments from strains BPSRB4 and 14 were sequenced and submitted to NCBI GenBank with accession numbers KX709840 and KX709841. The sequenced fragments from strains BPSRB4 and BPSRB14 showed 97% homology with other acdS gene in BLAST analysis.
Plant growth promoting and disease suppression effect
The two isolates BPSRB4 and BPSRB14, which were identified as Bacillus amyloliquefaciens, were further evaluated for growth promotion and disease suppression potential on chilli seedlings, under greenhouse conditions (Fig. 5). Application of isolate BPSRB14 resulted in the greatest increase in shoot and root length of chilli plants when compared with the control after 30 and 45 days of sprouting. After 45 days, decrease in disease incidence was observed in both the tested isolates, and strain BSPRB4 showed the greatest decrease in disease index (37.6%) as compared to the control (48.7%) (Fig. 6).
Evaluation of plant growth promoting potential of isolates Bacillus amyloliquefaciens strain BPSRB4 and Bacillus amyloliquefaciens strain BPSRB14 to show growth characteristics of chilli seedlings under greenhouse conditions after application of strains. a Growth of chilli plants, control, BPSRB4 and BPSRB14, under greenhouse conditions; b Comparison of shoot lengths of chilli plants: control, BPSRB4 and BPSRB14; c Comparison of root lengths of chilli plants: control, BPSRB4 and BPSRB14; d Measurement of shoot and root lengths of plants at 30 days after bacterial inoculation (isolates BPSRB4 and BPSRB14). e Shoot and root lengths of treated and control plants at 45 days after bacterial inoculation. f Weight of wet plants after 30 and 45 days after bacterial treatment. The results were compared by Students t test (*corresponds to p < 0.05, **corresponds to p < 0.005). The error bars represent the standard deviation
Disease suppression potential of isolates Bacillus amyloliquefaciens strain BPSRB4 and Bacillus amyloliquefaciens strain BPSRB14 at 30 and 45 days on chilli seedlings against F. oxysporum f. sp. capsici. The results were compared by Students t test (*corresponds to p < 0.05, **corresponds to p < 0.005). The error bars represent the standard deviation
Discussion
The PGPR enhance growth and productivity of agronomically important crops by colonizing on the surface or in the interior of roots (Dutta et al. 2015; Passari et al. 2015a). In the current study, 32 bacteria were isolated from rhizospheric soil of turmeric (C. longa) plants from two locations of India. These were screened for a broad spectrum of plant growth promoting attributes and their antagonistic potential against fungal phytopathogens.
Besides showing various PGP activities directly, PGPR can also protect plants indirectly by inhibiting soil-borne pathogens (Bakker et al. 2013). Similar findings were reported previously from bacterial isolates recovered from different rhizospheric soils (Kareem et al. 2014). Furthermore, the obtained isolates demonstrated significant in vitro PGP activity like phosphorous solubilization, ammonia production, IAA production, siderophore production and extracellular enzyme (catalase, amylase, cellulase and xylanase) production.
Among the proposed mechanisms for phosphate solubilization efficiency, Liu et al. (2014) had demonstrated that the production of gluconic acid, lactic acid, malic acid, succinic acid, formic acid, citric acid, malonic acid and tartaric acid are the most common acids which are responsible for phosphate solubilization. In this study, 26 (81.2%) isolates showed phosphate solubilization potential at varying levels by forming clear halo zones surrounding the colony on PKV agar plates and a significant decrease in pH of the medium was recorded, which indicated the production of acids. Previous researchers suggested that phosphate solubilization occurs mainly due to production of microbial metabolites with organic acids which decreases the pH of the culture media (Sahin et al. 2004). Here, the Bacillus amyloliquefaciens (strain BPSRB4) showed the highest phosphate solubilization activity after 5 days, similar to the activity of Bacillus sp. PnB 1 reported by Jasim et al. (2013) who stated that Bacillus sp. strain PnB1 exhibited the greatest phosphate solubilization efficiency, among 12 bacterial strains obtained from Piper nigrum.
Siderophore production is another indirect mechanism of PGPR to enhance plant growth along with extracellular enzyme (e.g. catalase, cellulase xylanase and amylase) production (Kavamura et al. 2013) and ammonia production (Marques et al. 2010; Minaxi et al. 2012). Among the isolates tested for PGPR in the current study, 18 (56.25%) showed in vitro siderophore production. Interestingly, all the isolates which showed antagonistic potential were positive for siderophore production. It has been reported that the ability of PGPR to produce siderophore is directly related to the antagonistic potential, as siderophore production deprive the phytopathogenic microflora from iron, thus limiting their growth (Kloepper et al. 1980; Wahyudi et al. 2011). B. amyloliquefaciens strain BPSRB 14 produced the highest amount of siderophore, which is in agreement with Clark et al. (2014), who stated that B. amyloliquefaciens ATCC 23843 cultures grown with ferric ammonium citrate as the iron source showed production of siderophore.
Among lytic enzymes, cellulase is important for the functioning of depolymerization of cellulase into fermentable sugar (Xing-hua et al. 2009). Screening of cellulase production on CMC agar plates amended with 1% CMC showed a clear zone around the colonies in 27 (84.3%) isolates. Quantitative estimation results showed that cellulase production was ranged from 1.84 to 7.86 IU/ml, which was higher as compare to Kumar et al. (2012b), who stated that 60% of the isolates showed 0.40 to 0.75 IU/ml of cellulase production. In the current study, Bacillus amyloliquefaciens (strain BPSRB4) demonstrated the highest amount of cellulase production activity (7.84 IU/ml). Similarly, several researchers have previously screened rhizospheric bacteria for cellulase production and correlated that activity with their plant growth promoting abilities (Singh et al. 2004). Further, isolate Bacillus amyloliquefaciens strain BPSRB4 produced the greatest amount of amylase enzyme (8.24 IU/ml) which is similarly reported by other research on bacteria isolated from other sources (Swain et al. 2006; Deb et al. 2013). In addition, isolate Bacillus amyloliquefaciens strain BPSRB14 showed the greatest xylanase enzyme (7.42 IU/ml) production. This finding was similarly reported by Amore et al. (2015), who isolated Bacillus amyloliquefaciens strain XR44A from western ghat region, which produced xylanase enzyme (10.5 IU/ml). All the rhizospheric bacteria analyzed in the current study exhibited catalase production which is in agreement with Kumar et al. (2012a) who showed that rhizospheric bacteria having PGP activity produced catalase.
Ammonia production also plays an important role in plant growth by accumulating nitrogen and increasing root and shoots growth as well as plant biomass (Marques et al. 2010). Among the tested isolates in the present study, Bacillus amyloliquifaciens strains BPSRB4 and BPSRB14 produced the highest amounts of ammonia.
All isolates screened for PGP activities were identified based on 16S rRNA gene sequence similarity and showed 98–100% similarity with type strains from NCBI GenBank database. Phylogenetic analysis based on 16S rRNA gene sequences clearly showed that the Gram positive Bacillus and Staphylococcus were clustered separately and formed different clades among the Gram positive bacterial isolates. Likewise, among the Gram negative bacteria three gram negative genera formed different clades. Similar findings were demonstrated by Jasim et al. (2013). To the best of our knowledge, isolate BPSRB31 (Sphingomonas canadensis) and BPSRB1 (Lysinibacillus varians) were isolated for the first time from rhizospheric soil of Curcuma longa plant though, Zhu et al. (2014) isolated Lysinibacillus varians from sediments of river and Abraham et al. (2013) isolated Sphingomonas canadensis sp. nov. from water.
The results of this study demonstrated that the plants treated with Bacillus amyloliquifaciens strains BPSRB4 and BPSRB14 showed increased root length, shoot length and plant weight as compare to the control after 30 and 45 days of inoculation. These results are in agreement with previous reports that stated that rhizosphere bacteria treatment increased plants roots, shoots and biomass (Goudjal et al. 2013; Liu et al. 2016). In addition, in the current study isolates BPSRB4 and BPSRB14 also demonstrated antifungal activity against F. oxysporum f. sp. Capsici, under green-house condition. These Bacillus amyloliquefaciens with effective biocontrol activity are promising for use in the agricultural sector for plant growth promotion to suppress fungal diseases.
References
Abbamondi, G. R., Tommonaro, G., Weyens, N., Thijs, S., Sillen, W., et al. (2016). Plant growth promoting effects of rhizospheric and endophytic bacteria associated with different tomato cultivars and new tomato hybrids. Chemical and Biological Technologies in Agriculture, 3, 1.
Abraham, W. R., Estrela, A. B., Rohde, M., Smit, J., & Vancanneyt, M. (2013). Prosthecate sphingomonads: Proposal of Sphingomonas canadensis sp. nov. International Journal of Systamatic and Evolutionary Microbiology, 63, 3214–3219.
Amore, A., Parameswaran, B., Kumar, R., Vinciguerra, L. R., Marcolongo, L., et al. (2015). Application of a new xylanase activity from Bacillus amyloliquefaciens XR44A in brewer's spent grain saccharification. Journal of Chemical Technology and Biotechnology, 90(3), 573–581.
Antoun, H., & Prevost, D. (2005). Ecology of plant growth promoting rhizobacteria. In Z. A. Siddiqui (Ed.), PGPR: Biocontrol and biofertilization (pp. 1–38). Netherlands: Springer.
Ariffin, H., Abdullah, N., Umi-Kalsom, M. S., Shirai, Y., & Hassan, M. A. (2006). Production and characterisation of cellulase by Bacillus pumilus eb3. International Journal of Engineering and Technology, 3(1), 47–53.
Bakker, P. A., Berendsen, R. L., Doorrnbos, R. F., Wintermans, P. C., & Pieterse, C. M. (2013). The rhizosphere revisited: Root microbiomics. Frontiers in Plant Science, 4, 1–7.
Bal, H. B., Das, S., Dangar, T. K., & Adhya, T. K. (2013). ACC deaminase and IAA producing growth promoting bacteria from the rhizosphere soil of tropical rice plants. Journal of Basic Microbioliology, 53, 972–984.
Bergey, D. H., & Holt, J. G. (2000). Bergey’s manual of determinative bacteriology (9th ed.). Philadelphia: PA, Lippincott WilliamsandWilkins.
Biari, A., Gholami, A., & Rahmani, H. A. (2008). Growth promotion and enhanced nutrient uptake of maize (Zea mays L.) by application of plant growth promoting rhizobacteria in arid region of Iran. Journal of Biological Sciences, 8, 1015–1020.
Bredholdt, H., Galatenko, O. A., Engelhardt, K., Fjaervik, E., Terekhova, L. P., et al. (2007). Rare actinomycete bacteria from the shallow water sediments of the Trondheim fjord, Norway: Isolation, diversity and biological activity. Environomental Microbiology, 9, 2756–2764.
Breidenbach, B., Pump, J., & Dumont, M. G. (2016). Microbial community structure in the rhizosphere of rice plants. Frontiers in Microbiology, 6, 1–12.
Bric, J. M., Bostock, R. M., & Silverstone, S. E. (1991). Rapid In situ assay for indoleacetic acid production by bacteria immobilized on a nitrocellulose membrane. Applied and Environmental Microbiology, 57, 535–538.
Cappucino, J. C., & Sherman, N. (1992). Microbiology: A laboratory manual (pp. 125–179). Cummings Publishing Company, New York: Benjamin.
Chattopadhyay, I., Kaushik, B., Uday, B., & Banerjee, R. K. (2013). Turmeric and curcumin: Biological actions and medicinal applications. Current Science, 87(1), 44–53.
Clark, D., Youngblood, C., Taplin, M., Brown, E., Williams, B. S., et al. (2014). Impact of iron availability on Bacillus amyloliquefaciens growth. Advances in Microbiology, 4, 962–967.
Datta, M., Sengupta, C., & Pandit, M. K. (2010). Isolation and characterization of bacterial isolates from chilli (Capsicum annuum L.) rhizosphere as potent plant growth promoter. Journal of Crop and Weed, 6(2), 50–58.
Deb, P., Talukdar, S. A., Mohsina, K., Sarker, P. K., & Sayem, S. A. (2013). Production and partial characterization of extracellular amylase enzyme from Bacillus amyloliquefaciens P-001. Springer Plus, 2, 1–12.
Deepa, C. K., Dastager, S. G., & Pandey, A. (2010). Isolation and characterization of plant growth promoting bacteria from non-rhizospheric soil and their effect on cowpea (Vigna unguiculata (L.) Walp.) seedling growth. World Journal of Microbiology and Biotechnology, 26, 1233–1240.
Drogue, B., Doré, H., Borland, S., Wisniewski-Dyé, F., & Prigent-Combaret, C. (2012). Which specificity in cooperation between phytostimulating rhizobacteria and plants. Research in Microbiology, 163, 500–510.
Dutta, J., Handique, P. J., & Thakur, D. (2015). Assessment of Culturable tea Rhizobacteria isolated from Tea Estates of Assam, India for growth promotion in commercial tea cultivars. Frontiers in Microbiology, 6, 1–13.
El-Sayed, W. S., Akhkha, A., El-Naggar, M. Y., & Elbadry, M. (2014). In vitro antagonistic activity, plant growth promoting traits and phylogenetic affiliation of rhizobacteria associated with wild plants grown in arid soil. Frontiers in Microbiology, 5, 1–11.
Felsenstein, J. (1985). Confidence limits of phylogenies: An approach using the bootstrap. Evolution, 39(4), 783–791.
Ghose, T. K. (1987). Measurement of cellulase activities. Pure and Applied Chemistry, 59(2), 257–268.
Goudjal, Y., Toumatia, O., Yekkour, A., Sabaou, N., Mathieu, F., et al. (2013). Biocontrol of Rhizoctonia solani damping off and promotion of tomato plant growth by endophytic actinomycetes isolated from native plants of Algerian Sahara. Microbiological Research, 169, 59–65.
Gregory, P. J., Sperry, M., & Wilson, A. F. (2008). Dietary supplements for osteoarthritis. American Family Physician, 77(2), 177–184.
Hankin, L., & Anagnostakis, S. L. (1975). The use of solid media for detection of enzyme production by fungi. Mycologia, 67, 597–607.
Hassan, M. N., Afghan, S., & Hafeez, F. Y. (2010). Erratum to: Suppression of red rot caused by Colletotrichum falcatum on sugarcane plants using plant growth-promoting rhizobacteria. BioControl, 55, 531–542.
Jasim, B., Jimtha, J. C., Mathew, J., & Radhakrishnan, E. K. (2013). Plant growth promoting potential of endophytic bacteria isolated from Piper nigrum. Plant Growth Regulation, 71, 1–11.
Ji, S. H., Gururani, M. A., & Chun, S. C. (2014). Isolation and characterization of plant growth promoting endophytic diazotrophic bacteria from Korean rice cultivars. Microbiological Research, 169, 83–98.
Kareem, M. A., Aboud, H. M., Saood, H. M., & Shibly, M. K. (2014). Antagonistic activity of some plant growth rhizosbacteria to F. graminearum. International Journal of phytopathology, 03(01), 49–54.
Kavamura, V. N., Santos, S. N., Da-Silva, J. L., Parmaa, M. M., Avilaa, L. A., et al. (2013). Screening of Brazilian cacti rhizobacteria for plant growth promotion under drought. Microbiolological Research, 168, 183–191.
Kloepper, J. W., Leong, J., Teintze, M., & Schroth, M. N. (1980). Enhanced plant growth by siderophores produced by plant growth promoting rhizobacteria. Nature, 268, 885–886.
Kumar, P., Dubey, R. C., & Maheshwari, D. K. (2012a). Bacillus strains isolated from rhizosphere showed plant growth promoting and antagonistic activity against phytopathogens. Microbiolological Research, 167, 493–499.
Kumar, A., Kumar, A., Devi, S., Patil, S., Payal, C., et al. (2012b). Isolation, screening and characterization of bacteria from rhizospheric soils for different plant growth promotion (PGP) activities: An in vitro study. Recent Research in Science and Technology, 4(1), 01–05.
Liu, F. P., Liu, H. Q., Zhou, H. L., Dong, Z. G., Bai, X. H., et al. (2014). Isolation and characterization of phosphate solubilizing bacteria from betel nut (Areca catechu) and their effects on plant growth and phosphorus mobilization in tropical soils. Biology and Fertility of Soils, 50, 927–937.
Liu, K., Garrett, C., Fadamiro, H., & Kloepper, J. W. (2016). Antagonism of black rot in cabbage by mixtures of plant growth-promoting rhizobacteria (PGPR). BioControl. https://doi.org/10.1007/s10526-016-9742-3.
Manivannan, M., Ganesh, P., Suresh, K. R., Tharmaraj, K., & Shiney, R. B. (2012). Isolation, screening, characterization and antagonism assay of PGPR isolates from rhizosphere of rice plants in Cuddalore district. International Journal of Pharmaceutical and Biological Archive, 3(1), 179–185.
Marques, A. P. G. C., Pires, C., Moreira, H., Rangel, A. O. S. S., & Castro, P. M. L. (2010). Assessment of the plant growth promotion abilities of six bacterial isolates using Zea mays as indicator plant. Soil Biolology and Biochemistry, 42, 1229–1235.
Mena-Violante, H. G., & Olalde-Portugal, V. (2007). Alteration of tomato fruit quality by root inoculation with plant growth-promoting rhizobacteria (PGPR): Bacillus subtilis BEB-13bs. Scientia Horticulturae, 113, 103–106.
Minaxi, L. N., Yadav, R. C., & Saxena, J. (2012). Characterization of multifaceted Bacillus sp. RM-2 for its use as plant growth promoting bioinoculant for crops grown in semi arid deserts. Applied Soil Ecology, 59, 124–135.
Mohite, B. (2013). Isolation and characterization of indole acetic acid (IAA) producing bacteria from rhizospheric soil and its effect on plant growth. Journal of Soil Science and Plant Nutrition, 13(3), 638–649.
Nautiyal, C. S. (1999). An efficient microbiological growth medium for screening phosphate solubilizing microorganisms. FEMS Microbiology Letters, 170, 265–270.
Pandey, P., Sahgal, M., Maheswari, D. K., & Johri, B. N. (2004). Genetic diversity of rhizobia iisolated from medicinal legumes growing in the sub-himalayan region of Uttaranchal. Current Science, 86(1), 2002–2207.
Passari, A. K., Mishra, V. K., Saikia, R., Gupta, V. K., & Singh, B. P. (2015a). Isolation, abundance and phylogenetic affiliation of endophytic actinomycetes associated with medicinal plants and screening for their in vitro antimicrobial biosynthetic potential. Frontiers in Microbiology, 6, 1–13.
Passari, A. K., Mishra, V. K., Gupta, V. K., Yadav, M. K., Saikia, R., et al. (2015b). In Vitro and In Vivo plant growth promoting activities and DNA fingerprinting of antagonistic endophytic actinomycetes associates with medicinal plants. PloS One, 10(9), e0139468.
Philippot, L., Raaijmakers, J. M., Lemanceau, P., & Der-Putten, W. H. V. (2013). Going back to the roots: The microbial ecology of the rhizosphere. Nature Reviews Microbiology, 11, 789–799.
Qin, S., Li, J., Chen, H. H., Zhao, G. Z., & Zhu, W. Y. (2009). Isolation, diversity and antimicrobial activity of rare actinobacteria from medicinal plants of tropical rain forests in Xishuangbanna, China. Applied and Environmental Microbiology, 75, 6176–6186.
Sahin, F., Cakmakci, R., & Kanta, F. (2004). Sugar beet and barley yields in relation to inoculation with N2-fixing and phosphate solubilizing bacteria. Plant and Soil, 265, 123–129.
Saitou, N., & Nei, M. (1987). The neighbor-joining method: A new method for reconstructing phylogenetic trees. Molecular Biology and Evolution, 4, 406–425.
Schwyn, B., & Neilands, J. B. (1987). Universal chemical assay for the detection and determination of siderophores. Analytical Biochemistry, 160, 47–56.
Shanmugam, V., & Kanoujia, N. (2011). Biological management of vascular wilt of tomato caused by Fusarium oxysporum f. Sp. lycospersici by plant growth promoting rhizobacterial mixture. Biological Control, 57, 85–93.
Singh, J., Batra, N., & Sobti, R. C. (2004). Purification and characterization of alkaline cellulase produced by a novel isolate Bacillus sphaericus JS1. The Journal of Industrial Microbiology and Biotechnology, 31(2), 51–56.
Somers, E., Vanderleyden, J., & Srinivasan, M. (2004). Rhizosphere bacterial signalling: A love parade beneath our feet. Critical Reviews in Microbiology, 30, 205–240.
Sudha, S. N., Jayakumar, R., & Sekar, V. (1999). Introduction and expression of the cry1Ac gene of Bacillus thuringiensis in a cereal-associated bacterium. Bacillus polymyxa. Current Microbiology, 38, 163–167.
Swain, M. R., Kar, S., Padmaja, G., & Ray, R. C. (2006). Partial characterization and optimization of production of extracellular α-amylase from Bacillus subtilis isolated from culturable cow dung microflora. Polish Journal of Microbiology, 55(4), 289–296.
Teather, R. M., & Wood, P. J. (1982). Use of Congo red-polysaccharide interactions in enumeration and characterization of cellulolytic bacteria from the bovine rumen. Applied and Environmental Microbiology, 43, 777–780.
Thompson, J. D., Gibson, T. J., Plewniak, F., Jeanmougin, F., & Higgins, D. G. (1997). The Clustal X windows interface: Flexible strategies for multiple sequence alignment aided by quality analysis tools. Nucleic Acids Research, 24, 4876–4882.
Wahyudi, A. T., Astuti, R. P., Widyawati, A., & Nawangsih, A. A. (2011). Characterization of Bacillus sp. strains isolated from rhizosphere of soybean plants for their use as potential plant growth for promoting rhizobacteria. Journal of Microbiology and Antimicrobials, 3, 34–40.
Xing-hua, L., Hua-jun, Y., Bhaskar, R., Dan, W., Wan-fu, Y., et al. (2009). The most stirring technology in future: Cellulase enzyme and biomass utilization. Journal of Microbiology and Biotechnology, 1(1), 229–233.
Zehnder, G. W., YAO, C., Murphy, J. F., Sikora, E. R., & Kloepper, J. W. (2000). Induction of resistance in tomato against cucumber mosaic cucumovirus by plant growth-promoting rhizobacteria. BioControl, 45, 127–137.
Zhu, C., Sun, G., Chen, X., Guo, J., & Xu, M. (2014). Lysinibacillus varians sp. nov., an endospore forming bacterium with a filament to rod cell cycle. International Journal of Systematic and Evolutionary Microbiology, 64, 3644–3649.
Acknowledgements
This work was supported by grants sanctioned to BPS from the Science and Engineering Research Board (SERB), Department of Science and Technology, the Government of India, New Delhi under Empowerment and Equity Opportunities for Excellent in Science (SERB/F/8195/2015-16). BPS is also thankful to University Grants Commission (UGC), New Delhi for funding a Major Research Project. The authors wish to thank the Department of Biotechnology for the establishment of DBT-BIF centre and DBT-state Biotech Hub in the Department, which has been used for the present study.
Author information
Authors and Affiliations
Corresponding author
Ethics declarations
Authors declared that this manuscript have not published elsewhere. All the authors have read very carefully and approved current version of this manuscript. All authors also declared that the data or images have not manipulated. This article does not contain any experiments with human participants or animals.
Conflict of interest
The authors declare that they have no conflict of interest.
Rights and permissions
About this article
Cite this article
Passari, A.K., Lalsiamthari, P.C., Zothanpuia et al. Biocontrol of Fusarium wilt of Capsicum annuum by rhizospheric bacteria isolated from turmeric endowed with plant growth promotion and disease suppression potential. Eur J Plant Pathol 150, 831–846 (2018). https://doi.org/10.1007/s10658-017-1325-3
Accepted:
Published:
Issue Date:
DOI: https://doi.org/10.1007/s10658-017-1325-3